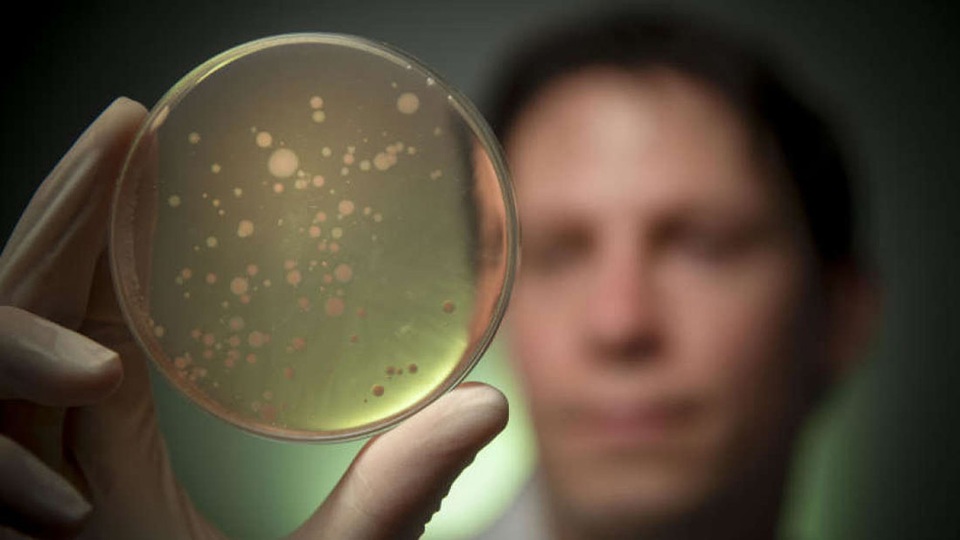
Hơn 100 loài mới được phát hiện trong… ruột con người - 1

Hơn 100 loài mới được phát hiện trong… ruột con người
(Dân trí) - Bên trong mỗi con người là một “điểm nóng đa dạng sinh học” với hàng trăm loài sinh vật khác nhau mà bạn có thể hoàn toàn không biết.
Ruột của con người chứa rất nhiều loài vi khuẩn và đương nhiên đó sẽ là nơi có nhiều khám phá đặc biệt mà có thể nhiều người chưa từng nghĩ đến.
Tiến sĩ Samuel Forster thuộc Viện Hudson, Australia, là một trong những tác giả đầu tiên báo cáo phần lớn các loài có trong các mẫu phân của 20 cư dân Anh và Canada có những nhận định đáng chú ý.
Theo tiến sĩ Samuel Forster, điều này chỉ có thể đưa ra một dấu hiệu nhỏ về sự đa dạng của các loài đặc biệt trong dân số loài người. Bước đầu đã xác định được 273 loài vi khuẩn, trong đó 105 loài hoàn toàn chưa được biết đến trước đó và 68 loài khác chưa được giải trình tự trước đó. Nhiều loài có nhiều chủng khác nhau.
Nhà nghiên cứu Forster chia sẻ, ước tính số lượng loài vi khuẩn sống ở người trên khắp thế giới lên tới 5.000 nhưng mỗi người trong chúng ta có thể chỉ có khoảng 200 loài.
Thực tế, hệ sinh thái trong ruột của con người rất ít được chú ý bởi vì nó rất khó để nuôi cấy.
Forster giải thích việc phát triển một mầm bệnh duy nhất khiến chúng ta bị bệnh bằng cách thống trị tạm thời thường là dễ dàng.
Trước những thực tế được nêu ra, nghiên cứu này sẽ dẫn đến việc tạo ra một cơ sở dữ liệu công cộng lớn nhất và toàn diện nhất về vi khuẩn đường ruột liên quan đến sức khỏe con người.
Khôi Nguyên (Theo IFL Science)










